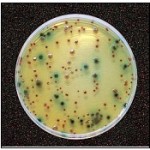
M

Medios de Cultivo Cromogénicos para una Detección Enzimática Precisa y Confiable
Los medios de cultivo cromogénicos representan la evolución de la microbiología moderna, al permitir la detección enzimática certera de los microorganismos diana, reduciendo significativamente los falsos positivos que suelen presentarse en los medios bioquímicos clásicos.
Gracias a su alta especificidad, estos medios permiten un ahorro de tiempo y recursos, al disminuir la necesidad de confirmaciones adicionales.
Laboratorios MICROKIT: Pioneros en Medios Cromogénicos Desde 1991
En Laboratorios MICROKIT somos pioneros en el diseño y fabricación de una amplia variedad de medios de cultivo cromogénicos, tanto sólidos (agares) como líquidos (caldos P/A).
Desde 1991, lideramos la innovación en microbiología aplicada con un claro compromiso por la calidad, la fiabilidad y la sostenibilidad.
Fuimos los primeros en estabilizar los sustratos cromogénicos, lo que nos permitió ser los primeros en ofrecer medios enzimáticos en formato deshidratado, con el cromógeno ya incorporado en el medio, garantizando la máxima estabilidad y facilidad de uso.
Innovación Reconocida a Nivel Internacional
En MICROKIT también fuimos los primeros en diseñar numerosos medios cromogénicos que hoy son utilizados en laboratorios de todo el mundo.
Nuestros productos abarcan desde medios específicos para patógenos hasta medios optimizados para el recuento de aerobios, siempre con resultados rápidos, claros y reproducibles.
Gama Completa de Medios de Cultivo Cromogénicos CROMOKIT
Nuestra línea CROMOKIT ofrece la gama más completa de medios cromogénicos disponibles en el mercado para el análisis microbiológico en distintos sectores:
- Alimentos y bebidas
- Aguas (potables, residuales, recreativas)
- Cosméticos y productos sanitarios
- Superficies y ambientes (aire, equipos, instalaciones)
Todos los medios CROMOKIT son diseñados y fabricados en España, con la calidad y experiencia que nos caracteriza desde los años 90.
⚗️ Formatos Disponibles
Ofrecemos todos nuestros medios tanto en versión deshidratada como en formato preparado, adaptados a las necesidades de cada laboratorio:
- Tubos
- Frascos
- Ampollas MF
- Placas herméticas PLAQUIS
- Kits P/A (Presencia/Ausencia)
Soluciones completas y fiables para cada tipo de análisis microbiológico.
Compromiso con la Innovación y la Calidad
En Laboratorios MICROKIT, cada desarrollo está respaldado por más de tres décadas de investigación y experiencia.
Nuestro objetivo es ofrecer medios cromogénicos que garanticen resultados rápidos, fiables y reproducibles, simplificando los procesos analíticos y optimizando los recursos de su laboratorio.
Para más información y precios actualizados sobre nuestros medios de cultivo cromogénicos no dude en ponerse en contacto con nosotros a través de nuestro correo electrónico microkit@microkit.es o por teléfono en el nº 91-897 46 16.
AGAR MUGPLUS (E.Coli y Coliformes), uno de nuestros primeros y más famosos medios cromogénicos
Estudie el folleto completo en:
https://www.microkit.es/pdf/CROMOKIT-2021.pdf
Conozca otra entrada del tema en nuestro blog:
https://www.medioscultivo.com/medios-cromogenicos-microkit-cromokit/
Prepárese para más de una sorpresa informativa cuando vea nuestro video sobre los medios Cromogénicos: https://www.youtube.com/watch?v=-JVPVWxY8ZE&t=271s


En la foto ¿ cuales son E.coli y cuales coliformes?
E.Coli: colonias azul-violetas
Coliformes: colonias rosas
Muchas gracias por su interés, para cualquier consulta o aclaración no dude en ponerse en contacto con nosotros de nuevo.